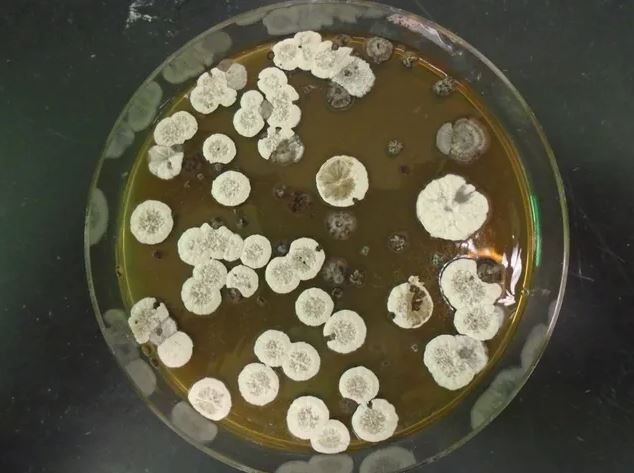
Đột phá: Nhiên liệu sinh học tạo ra từ vi khuẩn có thể thay thế chất đốt dùng trong ngành hàng không vũ trụ

Tìm kiếm: bầu-khí-quyển-của-trái-đất
Mới lúc bình minh, ta còn thấy mặt trời có màu đỏ, nhưng chỉ vài tiếng sau đã chuyển thành màu trắng đến lóa mắt và cuối cùng là màu đỏ rực rỡ khi hoàng hôn. Tại sao lại có sự thay đổi như vậy?
Màu xanh của bầu trời không phải từ sự phản chiếu của nước, thay vào đó màu sắc của nó liên quan đến ánh sáng tán xạ.
Trái đất chúng ta đang sống rất giàu tài nguyên nước, đại dương bao phủ 71% bề mặt trái đất và có khoảng 1,3 tỷ km khối nước trong toàn bộ đại dương.
Cho đến nay, giới khảo cổ vẫn không dám khai quật lăng mộ của Hoàng đế Tần Thủy Hoàng dù đã tìm thấy nó gần 50 năm. Vì sao?
Các nhà nghiên cứu đã đề xuất, một tảng đá bất thường, được phát hiện gần đây ở phía bắc châu Phi, có thể là "thiên thạch boomerang" đầu tiên được biết đến. Đó là một tảng đá có nguồn gốc từ Trái đất trước khi bị đẩy vào vũ trụ và sau đó quay trở lại Trái đất.
Bản tùy biến của Rolls-Royce Cullinan được hãng xe nước Anh chế tác tinh xảo và mang cảm hứng từ đường Kármán phân định giữa khí quyển Trái Đất với khoảng không vô tận của vũ trụ.
Theo Derrick Pitts, nhà thiên văn học tại Viện Franklin ở Philadelphia, thiên thạch này có thể đã hình thành từ 4 đến 5 tỷ năm trước
Theo nhận định của các nhà thiên văn học đến từ Vienna và Mỹ, sự gia tăng nhanh chóng về kích thước và tần suất dày đặc của các vụ nổ lớn thuộc chòm sao Nhân Mã sẽ sớm gây ảnh hưởng tiêu cực tới Trái Đất và sự sống trên hành tinh xanh của chúng ta.
Ảnh hưởng bởi tuyết rơi dày đặc, gió đông lạnh giá, những trận mưa như trút nước hay những đợt nắng nóng kéo dài… đã tạo ra những kiểu mây hiếm thấy trên bầu trời.
Các nhà nghiên cứu đã phát hiện ra những loại tinh thể chưa từng thấy trước đây ẩn trong những hạt bụi thiên thạch nhỏ bé được bảo quản hoàn hảo. Lớp bụi bị bỏ lại sau một thiên thạch khổng lồ phát nổ ở Chelyabinsk, Nga, cách đây 9 năm.
Loài người và nhiều sinh vật khác đã quen sống trong bầu không khí với hàm lượng oxy luôn ở mức 20,9 - 21%. Vậy điều gì sẽ xảy ra nếu nồng độ oxy tăng lên hoặc giảm nhanh đột ngột.
Đài quan sát Động lực học Mặt trời (SDO) của NASA đã phát hiện ra hiện tượng nhật thực vào ngày 29/6 vừa qua và đã chụp được bức ảnh cực đẹp về cảnh mặt trăng đi qua phía trước mặt trời.
Các nhà khoa học đã tìm thấy một loại vi khuẩn mới đầy hứa hẹn, và chúng có thể là một giải pháp thay thế cho nhiên liệu đốt trong không gian vũ trụ.
Các nhà khoa học Đức đã tìm thấy những vi tinh thể carbon kỳ quái trong thiên thạch Chelyabinsk nổi tiếng rơi xuống nước Nga năm 2013.
Một "họng súng vũ trụ" vừa tăng gấp đôi đường kính chỉ trong vòng 24 giờ, đã to gấp 2,5 lần Trái Đất và đang chĩa thẳng về phía chúng ta.
End of content
Không có tin nào tiếp theo